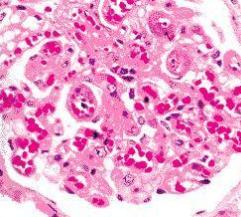
系统性红斑狼疮患者做人流对身体有什么影响

寻医问药网红斑狼疮为您提供详细的红斑狼疮概述,红斑狼疮疾病详情,红斑狼疮病因,红斑狼疮症状,红斑狼疮饮食保健,红斑狼疮治疗方法,红斑狼疮检查与鉴别,红斑狼疮的好医生

系统性红斑狼疮
800x595 - 104KB - JPEG

狼疮样综合征
500x704 - 47KB - JPEG

寻常狼疮
516x480 - 29KB - JPEG

实际上红斑狼疮的发病率现在在普通人群中已经
400x313 - 22KB - JPEG

周海媚红斑狼疮
322x483 - 110KB - JPEG

海口大三女生罹患红斑狼疮 家境贫困盼救助(图
500x344 - 37KB - JPEG
红斑狼疮瓶子_红斑狼疮瓶子价格_红斑狼疮瓶
640x480 - 68KB - JPEG

狼疮患者请勿与阳光亲密接触(图)
300x249 - 11KB - JPEG
系统性红斑狼疮患者做人流对身体有什么影响
241x217 - 16KB - JPEG

濮阳9岁女童身患红斑狼疮 和八旬奶奶相依为命
600x408 - 68KB - JPEG

盘状红斑狼疮
500x741 - 32KB - JPEG

女孩患红斑狼疮 获捐助已脱险
400x266 - 94KB - JPEG

红斑狼疮患者--食物禁忌
300x213 - 51KB - JPEG

19岁少女:我还能参加高考吗?-高考,安娜,ldquo
600x450 - 163KB - JPEG

陈敏之疑患红斑狼疮+盘点得了各种怪病的明星
300x367 - 23KB - JPEG